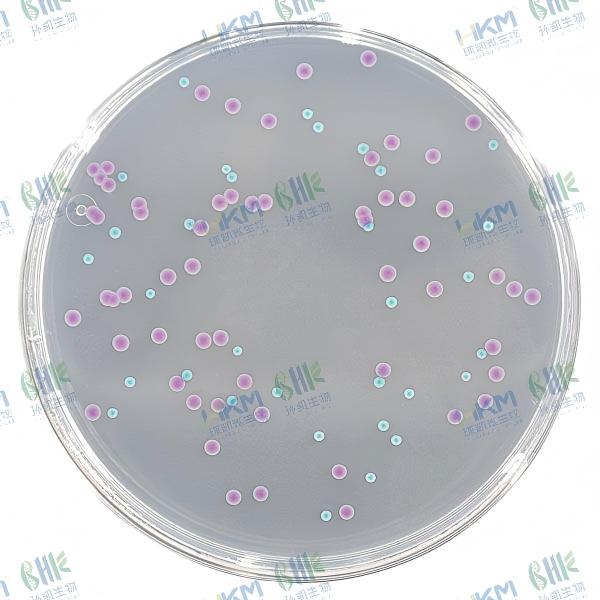
CRM003A 大肠菌群大肠杆菌(ECC)显色培养基平板 90mm×20个

已筛选结果:
显色培养基
x
产品类别:
全部
显色培养基
干粉培养基
药典培养基
颗粒培养基
染色液及微生物检测配套试剂
即用型成品培养基(瓶装/管装/袋装/平板): 成品平板培养基 瓶装液体培养基 成品斜面培养基 成品袋装培养基 成品管装培养基
三层包装无菌平板培养基(生产环境监测系列): 接触皿平皿培养基(无菌三层包装) 采集转运及表面洁净度检测试子 微生物测试纸片(HandyPlate快检)
核酸扩增法检测试剂盒(PCR快检): 实时荧光PCR检测试剂盒(荧光探针法) 恒温荧光法核酸快检试剂盒 DNA快速提取试剂盒系列 EasyID细菌生化鉴定试剂盒 HKM细菌生化鉴定管 培养基原材料
FSCC微生物质控品(菌株菌种): Q-Strain®定量质控菌种 定性质控标准菌株 水质定量质控样品 菌种保藏管 厌氧培养产品 灭菌验证指示产品 支原体培养基 参比培养基
即用型成品培养基(瓶装/管装/袋装/平板): 成品平板培养基 瓶装液体培养基 成品斜面培养基 成品袋装培养基 成品管装培养基
三层包装无菌平板培养基(生产环境监测系列): 接触皿平皿培养基(无菌三层包装) 采集转运及表面洁净度检测试子 微生物测试纸片(HandyPlate快检)
核酸扩增法检测试剂盒(PCR快检): 实时荧光PCR检测试剂盒(荧光探针法) 恒温荧光法核酸快检试剂盒 DNA快速提取试剂盒系列 EasyID细菌生化鉴定试剂盒 HKM细菌生化鉴定管 培养基原材料
FSCC微生物质控品(菌株菌种): Q-Strain®定量质控菌种 定性质控标准菌株 水质定量质控样品 菌种保藏管 厌氧培养产品 灭菌验证指示产品 支原体培养基 参比培养基
展开




行业应用:
展开




检测用途:
全部
真菌(霉菌、酵母、食用菌)培养基
细菌总数测定、增菌培养基
大肠菌群、粪大肠菌群、大肠杆菌检测培养基
肠杆菌科和阴沟肠杆菌检测培养基
大肠杆菌O157:H7检测培养基
沙门氏菌、志贺氏菌检测
金黄色葡萄球菌检测
溶血性链球菌检测
弧菌检测培养基
李斯特氏菌检测
梭状芽孢杆菌(产气荚膜梭菌)检测
绿脓杆菌(铜绿假单胞菌)检测
粪链球菌检测培养基
蜡样芽胞杆菌检测
乳酸菌检测
双歧杆菌检测
小肠结肠炎耶尔森氏菌检测
阪崎肠杆菌检测
空肠弯曲菌检测
椰毒假单胞菌酵米面亚种培养基
放线菌培养基
药敏试验培养基
生化鉴定培养基
嗜水气单胞菌检测
嗜肺军团菌检测培养基
嗜冷嗜热菌及耐酸菌检测培养基
维生素测定培养基
商业无菌检验系列培养基
运送培养基和菌种保存培养基
Ames试验培养基
抗生素微生物检定法培养基
欧洲、美国FDA标准培养基
抗干扰微生物培养基
致泻大肠埃希氏菌检测
洋葱伯克霍尔德菌检测
展开




-
 CRM018B1 胰蛋白胨胆盐X-葡萄糖醛酸苷(TBX)琼脂平板 90mm×20个
CRM018B1 胰蛋白胨胆盐X-葡萄糖醛酸苷(TBX)琼脂平板 90mm×20个编号:CRM018B1
规格:90mm×20个/盒
用途:用于食品中大肠埃希氏菌的快速检测(GB4789.38-2025)。
-
 CRM018 胰蛋白胨胆盐X-葡萄糖醛酸苷(TBX)琼脂培养基 1000mL
CRM018 胰蛋白胨胆盐X-葡萄糖醛酸苷(TBX)琼脂培养基 1000mL编号:CRM018
规格:1000mL配制用量/瓶
用途:用于食品中大肠埃希氏菌的快速检测(GB4789.38-2025)。